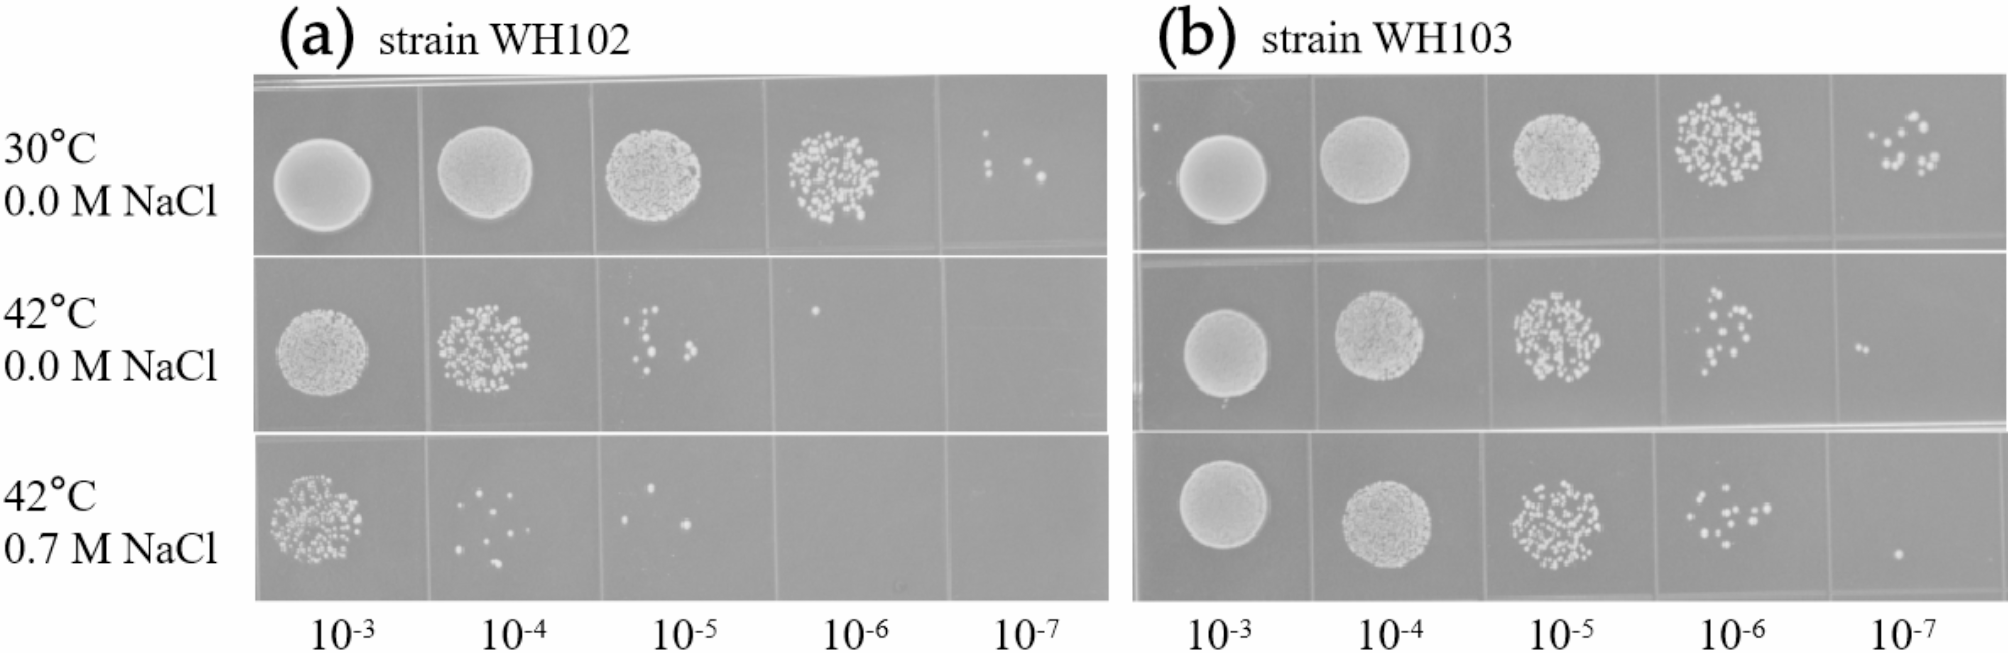
Fig. 2

Fig. 2
Identification of thermotolerant and osmotic pressure-tolerant strain. The (a) and (b) were 5 µL aliquots of tenfold serial dilutions of strain WH102 and strain WH103 were spotted on MMP [the mineral salts medium (MSM) with 0.10 mM PCA] agar plates with 0 M and 0.7 M NaCl, respectively. The spotted MMP plates were incubated for 3 days at 30 °C and 42 °C, respectively.
